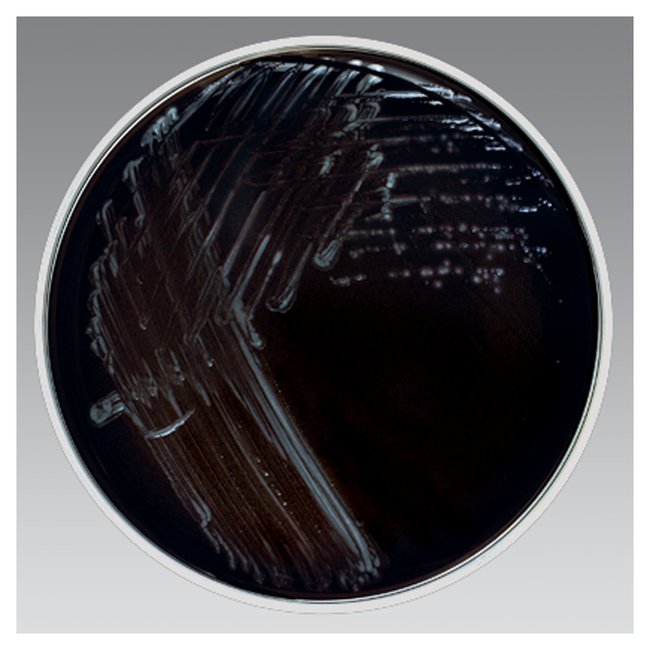

Remel Buffered Cye Selective Agar W/Polymyxin B, Anisomycin, Vancomycin, Use For Selective Isolation Of Legionella Spp, Pack Of 10
$ 252.45
|
|
Details:
Thermo Scientific™ Remel Buffered CYE Selective Agar wPolymyxin B, Anisomycin, Vancomycin (BCYE w/PAV) is used for selective isolation of Legionella spp.
Additional Information
| SKU | 1104859 |
|---|---|
| UOM | Pack of 10 |
| UNSPSC | 12161700 |
| Manufacturer Part Number | R01341 |
